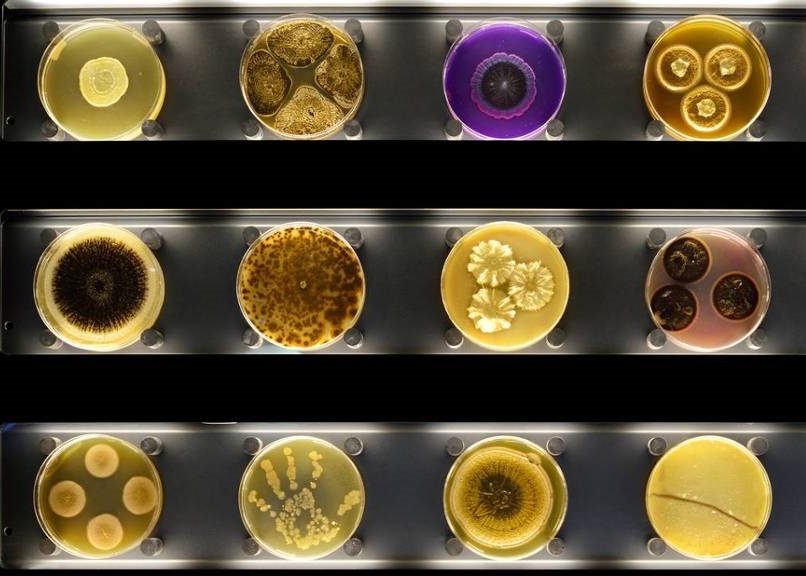
΢ﲩչʾ΢

全球首间“互动微生物动物园”在荷兰阿姆斯特丹揭幕
(神秘的地球报道)全球首间“互动微生物动物园”周二在阿姆斯特丹揭幕,展示这些占所有生物2/3及对地球未来至关重要的微小生物。
这家耗资1000万欧元建立的微生物博物馆,坐落阿姆斯特丹阿提斯皇家动物园旁边。参观者可透过3D显微镜观察微生物,亦可透过扫描器得知身上的微生物数量。当日荷兰王后索雷吉耶塔也有出席动物园的开幕仪式。
动物园园长巴利安于12年前灵机一触,想出成立微生物动物园,揭示一系列活微生物。他向记者表示,动物园历来趋于展示大自然一小部分,即较大型动物。他说:“今天,我们要展示微观大自然。”他认为,荷兰科学家列文虎克在17世纪透过显微镜观察微生物,但微生物在人类日常生活中的重要性被低估。
微生物博物馆展示林林总总微生物
参观者正透过检测器,扫描他们身上的微生物。
索雷吉耶塔(右)出席动物园开幕仪式
园长认为,微生物的重要性被低估。
参观者可透过3D显微镜观察微生物
他表示,微生物包括病毒、细菌、真菌和藻类等,往往与疾病有关。但是它们也对人类的生存至关重要,也对人类和地球的未来有愈来愈重要的作用。